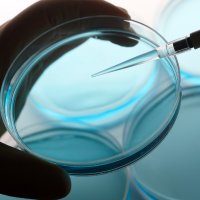

Catàleg de recursos per a primària, secundària, batxillerat, CFGS i societat
En aquesta pàgina trobareu totes les propostes destinades a docents i alumnat de primària i secundària, com tallers, conferències, xerrades, beques, visites concursos i altres recursos didàctics que us ofereix la URV.
-

Accions de la URV al Departament d'Educació i CFGS
- Totes les etapes
- Jornades, classes obertes i cicles de conferències
- De setembre a juliol. -

Beca-alumne Campus Experimenta
- Infantil, primària i ESO
- Tallers científics i xerrades científiques
- 26 i 27 de setembre -

Beques copatrocinades
- Batxillerat i CFGS
- Beques i ajuts
-

Beques Equitat
- Batxillerat i CFGS
- Beques i ajuts
-

Beques règim general
- Batxillerat i CFGS
- Beques i ajuts -

Ciència en un minut
- Totes les edats
- COMCIÈNCIA -

Conferències científiques
- Batxillerat i CFGS
- Conferències impartides en centres escolars
- Reserves del setembre al març -

Cotutorització de TDR i fet casteller
- Secundària, batxillerat i CFGS
- Suport cotutorització TDR -

Dia de la Ciència campus Terres de l'Ebre
- 4t d'ESO i batxillerat
- Taller en centres escolars
- De febrer a abril -

EstiURV
- 4t d’ESo i 1r de batxillerat
- Taller en centres escolars
- De juny a juliol -

E-talks: orienta el futur del teu alumnat
- Alumnat 3r d’ESO, 2n batxillerat i CFGS
- Recurs didàctic
- 20/03/2026 -

Experimenta en xarxa
- Pròximament
-

Fase local Olimpíada de Biologia de Catalunya
- Alumnat 2n batxillerat
- Competició
- Febrer -

Fase local Olimpíada de Geografia d'Espanya
- Batxillerat / Secundària
- Competició
- Març -

Fase local de la XVII Olimpíada d'Economia
- Alumnat 2n batxillerat
- Competició
- Març -

Guia didàctica del fet casteller
- Secundària, batxillerat i CFGS
- Recurs didàctic per a professorat -

Jornades de Portes Obertes URV
- Batxillerat i CFGS
- Visita espais URV
- D’octubre a maig -

Lliga de Debat
- 4t d’ESO, batxillerat i cicles formatius
- Concurs, premis, ajuts
- Inscripcions de setembre a octubre -

Materials del programa escolar del projecte APQUA de la URV
- Batxillerat i CFGS
- Taller
- Durant tot el curs -

Nit de la Recerca
- ESO, batxillerat, CFGS
- Divulgació, tallers
- Setembre-octubre -

Orientació als centres de secundària
- Secundària, batxillerat i CFGS
- Concurs, premi, ajut
- Juny -

Premi Federico Mayor Zaragoza
- Batxillerat, CFGS, ESO i primària
- Premi
- Sol·licituds entre gener i març -

Premis Consell Social de la URV a TDR
- Alumnat 2n batxillerat
- Concurs, premi, ajut
- Inscripcions primera quinzena de maig -

Premis Facultat de Ciències Jurídiques a TDR batxillerat i treball de síntesi CFGS
- Alumnat de 2n de batxillerat i últim curs de CFGS
- Concurs, premi, ajut
- Fins a mitjans de juny -

Premis Facultat de Turisme i Geografia a TDR
- Batxillerat, CGFS, Secundària
- Concurs, premi, ajut
- Convocatòria nual -

Premis Gerard Vergés a TDR batxillerat i treball de síntesi CFGS
- Alumnat de 2n de batxillerat i CFGS de centres de les Terres de l’Ebre
- Premis
- De març a juny -

Premis URV-Fòrum Trics als millors treballs de recerca
- 2n de batxillerat i 2n de CFGS
- Concurs, premi, ajut
- Inscripcions de gener a març -

Ruta teatralitzada sobre Antoni de Martí i Franquès
- Batxillerat i secundària
- Divulgació
- Novembre -

Ruta científica Lluís Pons d'Icart
- Batxillerat, ESO i ciutadania
- Divulgació
- D’abril a maig -

Talent Jove
- Batxillerat
- Taller
- D’octubre a juny -

Taller Fem Recerca
- Secundària, batxillerat i CFGS
- Taller
- D’octubre a febrer -

Taller Transició energètica i hidrogen verd
- Batxillerat i ESO
- Taller
- març a desembre -

Taller URV-AEQT "Setmana de la Ciència 2025"
- Alumnat 5è i 6è primària, ESO, batxillerat
- Taller a espais URV
- Del 3 al 7 i del 10 al 14 de novembre de 2025 -

URV-Alt Camp: Un món de Ciència i programa de visites educatives"
- Batxillerat, ESO i Primària
- Taller en centres escolars
- Fins a setembre -

URV-DOW: Un món de ciència
- Batxillerat, ESO i Primària
- Taller en centres escolars
- Fins al 21 setembre -

ToURV
- Batxillerat, CFGS, secundària
- Tallers, activitats -

URVocació
- Batxillerat i CFGS
- Divulgació
- De setembre a juny -

Xerrada "La ciència dels castells"
- Batxillerat, CFGS i ESO
- Conferència a centres escolars
- Durant el curs
-

Accions de la URV al Departament d'Educació i CFGS
- Totes les etapes
- Jornades, classes obertes i cicles de conferències
- De setembre a juliol -

Ajuts Pont
- Docents infantil, primària i secundària
- Ajut
- Setembre-juny -

Ciència en un minut
- Totes les edats
- COMCIÈNCIA -

Científiques en acció
- 1r i 2n d'ESO
- Recurs didàctic, suport professorat i alumnat de centres escolars
- Del 26/09/25 al 31/01/26 -

Conferències científiques
- Batxillerat i CFGS
- Conferència impartida en centres escolars
- Reserves del 16/09/25 al 28/03/26 -

Convocatòria Repte Experimenta a l'Aula
- Alumnes 1r i 2n d’ESO
- Taller impartit en centres escolars
- Inscripció de desembre a juny -

Copa Cangur
- ESO de les Terres de l’Ebre
- Competició
- Inscripcions octubre-novembre -

Cotutorització de TDR i fet casteller
- Secundària, batxillerat i CFGS
- Suport cotutorització TDR -

Crim Experimenta: resol un cas
- ESO
- Recurs didàctic
- Sol·licitud fins al novembre -

Dia de la Ciència campus Terres de l'Ebre
- 4t d'ESO i batxillerat
- Taller en centres escolars
- De febrer a abril -

EstiURV
- 4t d'ESO i 1r de batxillerat
- Taller en centres escolars
- Juny i juliol -

E-talks: orienta el futur del teu alumnat
- 3r d'ESO, 2n batxillerat i CFGS
- Recurs didàctic
- Març -

Experimenta en xarxa
- Pròximament
-

Fase local Olimpíada de Geografia d'Espanya
- Batxillerat / Secundària
- Competició
- Març -

First Lego League
- Primària i ESO
- Tecnologia i robòtica -

Guia didàctica del fet casteller
- ESO.
- Recurs didàctic per a professorat.
- Juny. -

Jornada d'innovació docent
- Totes les etapes
- Competició
- Durant el juliol -

Lliga de Debat
- 4t d'ESO, batxillerat i cicles formatius
- Concurs, premis, ajuts
- Inscripcions de setembre a octubre -

Materials del programa escolar del projecte APQUA de la URV
- Batxillerat i CFGS
- Taller
- Durant tot el curs -

Nit de la Recerca
- ESO, batxillerat, CFGS
- Divulgació, tallers
- Durant el setembre i l’octubre -

Orientació als centres de secundària
- Secundària, batxillerat i CFGS
- Concurs, premi, ajut
- Juny -

Premi CEPAC-Càtedra URV - TDR i el fet casteller
- Batxillerat i formació professional
- Concurs, premi, ajut
-

Premi Federico Mayor Zaragoza
- Secundària, primària, batxillerat i CFGS
- Premi
- Sol·licituds entre gener i març -

Premis Consell Social de la URV a TDR
- 2n batxillerat
- Concurs, premi, ajut
- Inscripcions: primera quinzena de maig -

Premis Facultat de ciències Jurídiques a: TDR batxillerat i Treball de síntesi CFGS
- Alumnat de 2n de batxillerat i últim curs de CFGS
- Concurs, premi, ajut
- Fins mitjans de juny -

Premis Facultat de Turisme i Geografia a TDR
- Batxillerat, CGFS, Secundària
- Concurs, premi, ajut
- Convocatòria nual -

Premis URV-Fòrum Trics als millors treballs de recerca
- 2n de batxillerat i 2n de CFGS
- Concurs, premi, ajut
- Inscripcions de gener a març -

Programa Kids' i Teens' Lab BASF-URV
- Primària i ESO
- Tecnologia, ciències -

Ruta teatralitzada sobre Antoni de Martí i Franquès
- Batxillerat i secundària
- Divulgació
-

Talent Jove
- Batxillerat
- Taller
- D'octubre a juny -

Taller URV-AEQT "Setmana de la Ciència 2025"
- 5è i 6è primària, ESO, batxillerat
- Taller en espais URV
- Novembre -

Taller Fem Recerca
- Secundària, batxillerat i CFGS
- Taller
- D'octubre a febrer -

Taller Transició energètica i hidrogen verd
- Batxillerat i ESO
- Taller
- març a desembre -

ToURV
- Batxillerat, CFGS, secundària
- Tallers, activitats -

URV-Alt Camp: Un món de ciència i programa de visites Educatives"
- Batxillerat, ESO i Primària
- Taller en centres escolars
- Fins a octubre -

URV-DOW: "Un món de Ciència"
- Batxillerat, ESO i Primària
- Taller en centres escolars
- Fins a setembre -

Xerrada "La ciència dels castells"
- Batxillerat, CFGS i ESO
- Conferència en centres escolars
- Durant el curs -

Ruta científica Lluís Pons d'Icart
- Batxillerat, ESO i ciutadania
- Divulgació
- Abril – maig
-

Ajuts Pont
- Docents infantil, primària i secundària
- Ajut
- Setembre-juny -

Ciència en un minut
- Totes les edats
- ComCiència -

Els insectes a l'escola: proteïna més sostenible
- 1r a 6è d’educació primària
- Taller en centres escolars
- D’octubre a maig -

Experimenta en xarxa
- Pròximament
-

Fira Experimenta: la gran festa de la ciència feta per joves
- 1r a 6è de primària
- Fira científica
- juny -

First Lego League
- Primària i ESO
- Tecnologia i robòtica -

Jocs científics per a l'aula: Splashcraft i Aquanet
- Primària
- Competició
- Durant tot el curs -

Jornada d'innovació docent
- Totes les etapes
- Competició
- Durant el juliol -

Materials del programa escolar del projecte APQUA de la URV
- Batxillerat i CFGS
- Taller
- Durant tot el curs -

Nit de la Recerca a Tarragona
- Infantil, primària i ESO
- Ciència i divulgació
- Setembre -

Participació en la Fira de Ciències FCEP
- Primària
- Tallers educació ambiental al jardí de les papallones
- Maig -

Premi Federico Mayor Zaragoza
- Primària, secundària, batxillerat i CFGS
- Premi
- Sol·licituds entre gener i març -

Programa Kids' i Teens' Lab BASF-URV
- Primària i ESO
- Tecnologia, ciències -

Programa Inspira STEAM
- Educació primària
- Taller, recurs didàctic
- 2n i 3r trimestre escolar -

Taller L'avellana a l'escola
- Primària
- Taller en centres escolars
- De setembre a desembre -
Taller URV-AEQT "Setmana de la Ciència 2025"
- 5è i 6è primària, ESO, batxillerat
- Taller en espais URV
- Novembre -

URV-Alt Camp: Un món de ciència i programa de visites educatives"
- Batxillerat, ESO i Primària
- Taller en centres escolars
- Fins a l’octubre -

URV-DOW: Un Món de Ciència
- Batxillerat, ESO i primària
- Taller en centres escolars
- Fins al setembre
-

Aperitius de ciència
- Ciutadania
- Divulgació ComCiència -

Ciència en un minut
- Tots els públics
- Divulgació ComCiència -

Concurs #Hilotesis
- Doctorands
- ComCiència -

La Ciència del Vi
- Tots els públics
- Divulgació ComCiència -

La Ciència se'n va de Festa
- Tots els públics
- Divulgació ComCiència -

Ruta científica Lluís Pons d'Icart
- Batxillerat, ESO i ciutadania
- Divulgació ComCiència
- Abril-maig -

Ruta teatralitzada sobre Antoni de Martí i Franquès
- Tots els públics
- Divulgació ComCiència -

#URVgoals
- Tots els públics
- Divulgació ComCiència -

Nit de la Recerca
- Ciutadania
- Divulgació ComCiència
- Setembre-octubre -

Pregunta a Plaça
- Ciutadania
- Divulgació ComCiència
Beques, ajuts i premis
Beques copatrocinades. Consell Social, Fundació Repsol i Diputació de Tarragona
Beques règim general
Premi CEPAC-Càtedra URV per a l'estudi del fet casteller per a treballs de recerca de temàtica castellera a secundària
Premis Consell Social de la URV a treballs de recerca de batxillerat
Premis URV-Fòrum Trics als millors treballs de recerca
Premis Gerard Vergés als TDR de batxillerat i als treballs de síntesi de CFGS
Col·laboració acadèmica
Científiques en acció, experimenta! Inspirar vocacions amb referents reals
Co-tutorització de treballs de recerca de secundària relacionats amb el fet casteller
Concurs / competició
Cursos
Divulgació centres educatius
Fira
Fira Experimenta: la gran festa de la ciència feta per joves!
Formació per a professorat
Orientació acadèmica
Co-tutorització de treballs de recerca de secundària relacionats amb el fet casteller
E-Talks: experiències inspiradores per orientar el futur del teu alumnat
Tallers divulgació científica
Científiques en acció, experimenta! Inspirar vocacions amb referents reals
Convocatòria Repte Experimenta a l'Aula
Convocatòria llicències beca-alumne Campus Experimenta: ciència gamificada per repensar l'aula
Crim Experimenta: resol un cas policíac experimentant
Dia de la Ciència al Campus Terres de l'Ebre
Taller "Els insectes a l'escola:una font de proteïna més sostenible"
Jocs científics per a l'aula: Splashcraft i Aquanet
Materials del Programa Escolar del Projecte APQUA de la URV
Ruta teatralitzada sobre Antoni de Martí i Franquès
Taller "L'avellana a l'escola"
Taller d'activitats experimentals URV-AEQT a la "Setmana de la Ciència 2025"
URV-Alt Camp "Un Món de Ciència" i "Programa de Visites Educatives"
Treballs de recerca
Co-tutorització de treballs de recerca de secundària relacionats amb el fet casteller
Premis Consell Social de la URV a treballs de recerca de batxillerat
Premis Gerard Vergés als TDR de batxillerat i als treballs de síntesi de CFGS



.png)
